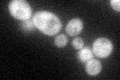
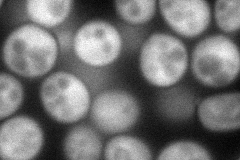
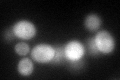
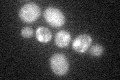

View description
RNA-binding protein proposed to be involved in translational regulation; binds specific categories of mRNAs, including those that contain upstream open reading frames (uORFs) and internal ribosome entry sites (IRES)
Localization:
Intensity:
Fold change:
Significance:
-
C’ GFP library in SD
cytosol54.44 -
N' NOP1pr-GFP in SD
cytosol122.203 -
N' TEF2pr-mCherry in SD

missing0 -
N' NATIVEpr-GFP in SD

missing0 -
N' TEF2pr-VC and Cyto-VN in SD

#N/A0 -
C’ GFP library in SD+DTT
cytosol53.370.98No -
C’ GFP library in SD+H2O2

cytosol62.221.14No -
C’ GFP library in Starvation Media
cytosol31.770.58No -
C’ GFP library on the background of Pup2-DaMP

cytosol -
C’ GFP library on the background of CCT mutant

cytosol53.30260.979066No
